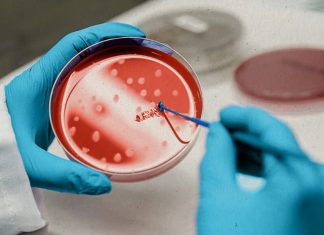
New study may reduce malignancy risk from stem cell therapies New study may reduce malignancy risk from stem cell therapies

Prevent metabolic syndrome in menopause: don’t retire
In these tough economic times, many menopausal women who would choose to retire from the workforce if they had their druthers must keep working...
New study evaluates who might benefit from statin therapy
The indications for statin therapy to lower cholesterol levels were expanded by the 2013 guidelines of the American College of Cardiology and the American...
CU-Boulder study: Old arteries returning to their younger conditions
In a press release, a new study by the University of Colorado Boulder have found an antioxidant that targets the mitochondria within a cell...
Parkinson’s disease three times more likely for meth users
There’s not a lot of good news in this world for meth users, so we’ll just throw this one on top of their bad...
Study: Living alone increases your risk of an early death
It might make the most sense for some people’s lifestyles to live alone, but it’s actually a problem. According to The Huffington Post, a...
New test for schizophrenia may change court system
Dr. Vivian Hook, professor with Skaggs School of Pharmacy and the University of California at San Diego School of Medicine, has developed a test...
Study: Depending on your heart attack risk, aspirin can do more...
New information shows 11.6 percent of patients prescribed aspirin therapy to prevent heart attacks or strokes shouldn’t actually be taking the medicine. According to...
New study may reduce malignancy risk from stem cell therapies
Scientists continue to make advances is stem cell research. A problem with the use of stem cells is the possibility of malignant cells developing....
Study: If you think you are ugly you might have abnormal...
According to a new study, if you obsess over your appearance your brain might be wired abnormally. Body dysmorphic disorder is a disabling but...
Researchers isolate stress-resistant stem cells from liposuction tissue
Liposuction is a procedure to rid the body of unwanted body fat. Now, UCLA researchers have found a use for that tissue. They have...